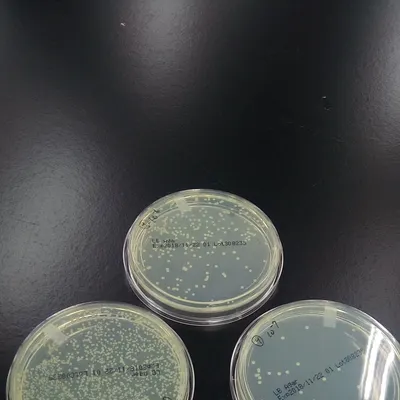
avatar-avatar

大約是在2024年初吧!由於知道要開處理廠,或是載運廢棄物,是需要字號的,再加上法規日趨嚴格,在現在這個ESG時代,再生循環肯定和回收廢棄物脫不了關係的,為了更上一層樓,我跟在做廢棄物的朋友請教後,我就報名了 中興大學的廢棄物甲級處理證照班。開啟了為6~9月份為期三個月的學習之旅,週末到校園上課,還真有點懷念大學的時光!

一袋書 - 十三門課厚厚疊過40公分,只能靠上課和實務的理解
我到教室上課時,其實學員數還不少,一班有將近40個人。班上的同學有業界的主管、還有座廢棄回收的二代,再來比較多就是大學生跟研究生,是就讀環工系所的同學。
說認真的,若不是有老師上課的投影片,還有老師們的上課功力,每本講義都厚厚的超過1.5公分,出社會已經10年的我,要啃真的啃不下去。只好靠上課時勤聽和勤做筆記,特別是老師說會考的就趕快再生畫線和當下記憶和理解,不過好在因為我們已經開始接觸廢棄物,也已經耕耘和請教專家們有一段時間,所以對於這些廢棄物的分類、處理、再利用、法規等等的,我倒是聽得蠻專注的。
只是會時不時就會聽到某些事情,未來可能會碰到或用到,比方說送焚化爐的量啦、進出場需要有什麼證明啦、甲乙丙級的處理量或是處理內容有哪些啦、焚化爐和再利用的爐和做法有哪些啦....等等等,我就會聽的比較仔細。
那我是算幸運,因為理工科畢業,可以直接報考乙級或是甲級,因為這個會處理到營建和有害事業廢棄物,跟物理化學比較有相關,所以我就直接報考要考13科的甲級證照班,不是「清運」,是「處理」。因為甲處證照有的話,是可以配合公司去申請甲乙丙的清運或是處理字號都是可以的!比較乾脆!想想當時還蠻勇敢的!
我上課的時候聽到相關的內容,就會配合自己的商業模式和營運,去跟GPT討論可行性,其實激盪和確認蠻多想法的,我課程中間也會去請教老師,以目前我們的事業體來說,需要怎麼運營合法,可以用什麼方式做循環經濟。

廢床需要被處理,不屬於有害廢棄物,沒有明文法規定義
我有詢問老師,我們的中間處理過程,如果做拆解破碎和後端再利用成為衣纖木環保建材的做法,老師說這是很好的方向,廢棄床墊各縣市堆積如山, 垃圾處理相當困擾,體積大不好搬運,工法複雜人工難處理。除裡的時間和費用都過高,需要新方案的突破。
這中間也感謝我們BNI的會員夥伴,陪伴我一起前往台中市環保局去請教科長,去看我們的工廠要從哪一個面向申請工廠登記,結果我們問了+尋遍了法規,科長說到,這個不是通案,只能做個案申請和審查,說我們可以先以「傢俱回收或傢俱製造」下去著手,因為這個代表在場內有床墊是很正常的,不管新舊。回收也是正常的。
後來我就在太平租了一個工廠,就開始我們的床墊拆解和嘗試再利用突破的事業。
我們敢租敢做,真的要很感謝上帝、感謝媽媽的愛。媽媽的保單,受益人是我和哥哥,幫助了我和哥哥更有底氣的開啟事業。媽媽在被天父爸爸接走以前,總是給我和哥哥鼓勵和支持,總是在我出門時說:「上帝與你同在,你就是成功的人!」這句話真的對我每天面對生活和挑戰,極其重要!真的感謝媽媽和有這份信仰。
13科考試的準備,屢敗屢戰最終過關!
我們差不多快9月的時候結束課程,那結束課程後到要考試前,嗯...不知道怎麼著,一直忙一直忙,講義一直晾在我的書桌旁邊的角落,剩下兩週前,我想說要開始迅速閱讀教科書,但我發現,我一本都看不下去啊!
想不到這個時代,手機和快速資訊,已經讓我靜不下來好好讀完一本書了。我想說順著慣性來完成讀書,想說一頁一頁拍照下來給GPT去閱讀整理,結果...檔案太多,一個聊天室根本吃不完全部。直接放棄,然後我上網遍尋考古題,還真的被我找到。只是上課時,老師也有說今年因為法規變化的關係,可能考古題不太管用。
但,沒辦法的辦法,只能硬上了!
我花了一個禮拜的時間,每天就想辦法,一個篇章的考古題,起碼都有300題起跳,有些甚至還到了500-600題,我的天哪!
結果,還是硬生生地想辦法,在兩天考試前,把考古題至少都做過一遍,然後記錄和嗨賴下來那些我做錯和重點,想辦法用「抱佛腳記憶法」。

好在感謝主,第一次考的時候,13科過了10科,大概分數是落在60-70分,少數一顆有80,只好再考第二次,順帶一提,只能考三次,三次不過要重修!不過好在,我已經過了10科,我哥鼓勵我,很厲害了啦!然後我又再接再厲,9月份沒考過,12月再考一次,結果,3科過二科,兩科一科62、一科64,只好二月份再考一次,終於!「60分!」PASS啦!太感謝了!邊忙邊考,考過台灣最高級的廢棄物的證照,甲級廢棄物。
那時候連前環保署副署長都恭賀!

知道是一回事,做到是一回事;理論和實務需要並進
當初報考這張證照,一方面是想要學習、二方面是在做床墊再生的事業上有個「認知」基礎和法律的觀念,當然還有一方面是要幫我們公司申請字號。
除了搬家,廢棄清運也可以一起處理。
感謝主,讓我有機會考過甲級處理證照,可以讓我們的再生事業有更好的認知基底,也讓我們家族事業可以有更好的利基點擴張!也感謝我哥、還有愛人Ruby持續的鼓勵。我真的做到了,一般人很難考過的,廢棄物甲級處理證照!
未完待續,敬請期待!
我是賦活再續-床墊再生計畫的發起人-阿岳,
感謝您們的閱讀!